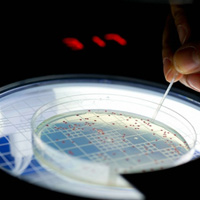
Tin tức trong ngày - Hồi sinh vi khuẩn sống cách đây 500 triệu năm

Nhà khoa học Nga tiêm vi khuẩn cổ đại để trở nên “bất tử”
Một nhà khoa học Nga tự tiêm vi khuẩn cổ đại 3,5 triệu năm tuổi với hy vọng có thể kéo dài tuổi thọ con người nói rằng, ông cảm thấy khỏe mạnh hơn và không bao giờ bị ốm.
Nhà khoa học Nga Anatoli Brouchkov tự tiêm vi khuẩn cổ đại với hy vọng kéo dài tuổi thọ.
Theo The Sun (Anh), nhà khoa học Nga tuyên bố vi khuẩn cổ đại giúp ông khỏe mạnh, sung sức và làm việc hiệu quả hơn sau khi tự tiêm nó cho mình.
Anatoli Brouchkov, đến từ Đại học Moscow cho rằng, vi khuẩn Bacillus F 3,5 triệu năm tuổi có thể là chìa khóa giúp con người bất tử.
Để kiểm tra giả thuyết này, ông Brouchkov tự tiêm vi khuẩn vào tĩnh mạch của bản thân và hoàn toàn bất ngờ trước kết quả.
"Tôi bắt đầu làm việc lâu hơn và không bị cảm trong hai năm qua", Brouchkov nói trên Siberian Times.
Ông Brouchkov lần đầu trước đó thử nghiệm vi khuẩn cổ đại trên chuột và phát hiện vi khuẩn giúp khôi phục khả năng sinh sản của chuột cái. Một thời gian ngắn sau đó, nhà khoa học Nga quyết định thử nghiệm ngay trên bản thân mình.
Vi khuẩn 3,5 triệu năm tuổi là chìa khóa giúp con người bất tử?
Tuy nhiên, Brouchkov thừa nhận việc ông không mắc bệnh không hoàn toàn do tiêm vi khuẩn. Nhà khoa học Nga hy vọng vi khuẩn Bacillus F sẽ được nghiên cứu lâm sàng trong tương lai để kiểm tra hiệu quả thực sự của nó.
"Chúng ta phải tìm ra cách vi khuẩn này giúp ngăn ngừa lão hóa, sử dụng vi khuẩn cổ đại để phục vụ lợi ích con người", ông Brouchkov nói.
Vi khuẩn Bacillus F 3,5 triệu năm tuổi được tìm thấy trong lớp băng vĩnh cửu nhưng nay có thể đã thoát ra môi trường ở Siberia. "Lớp băng vĩnh cửu đang tan ra. Tôi cho rằng vi khuẩn đã xâm nhập vào môi trường, nguồn nước và tồn tại trong cơ thể người dân địa phương", ông Brouchkov nhận định.
Nhà khoa học Nga cho rằng, loại vi khuẩn này có thể giúp con người sống lâu hơn. "Người Yakut đã tiếp nhận vi khuẩn Bacillus F từ nguồn nước trong thời gian dài. Tuổi thọ của họ cao hơn người dân ở quốc gia khác. Vì thế, tôi nghĩ rằng sẽ không có nguy hiểm nào xảy ra với tôi".